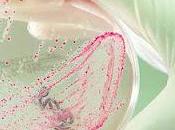
Infección Escherichia coli coli)

Arnal3000
 Descripción
Descripción
compartido
MIS BLOGS
-
El guppy, lebistes o pez millón
http://guppy-lebistes.blogspot.com/
El guppy (Poecilia reticulata), también conocido como el "pez millón", es una de las especies de agua dulce más populares peces de acuario en el mundo. Se trata de un pequeño miembro de la familia Poeciliidae [las hembras 4 a 6 cm de largo, los machos 2,5 a 3,5 cm de largo] y, como todos los demás miembros de la familia.
-
Tu Doctor Online
http://tudoctoronline.org/
Tu Doctor Online te permite hacer consultas y preguntas de medicina, enfermedades y medicamentos online. Recibe consejos y noticias de salud, En temas de Nutrición, Obesidad, Vejez, Sexualidad, Prevención de enfermedades. @TuDoctorOnline
ÚLTIMOS ARTÍCULOS (297)
-
¿Cómo mejorar el estreñimiento de manera natural?

Consejos para vencer el estreñimiento.Hay muchas causas de estreñimiento, lo primero es saber cual es el tipo de estreñimiento que te aqueja. Lo mas frecuente e... Leer el resto
Publicado el 30 agosto 2012 SALUD Y BIENESTAR -
¿Dolor al caminar? Caudicación Intermitente. Tratamiento

Caludicación intermitente por enfermedad vascular periféricaLa claudicación intermitente Es el síntoma más característico de la patología arterioesclerótica... Leer el resto
Publicado el 29 agosto 2012 SALUD Y BIENESTAR -
¿Cómo se utiliza el glucómetro?

Glucómetro, Lancetas y Tiras reactivas.¿Cómo se utiliza el glucómetro?Para utilizar el glucómetro para poder medir el azúcar en la sangre es necesaria una... Leer el resto
Publicado el 29 agosto 2012 SALUD Y BIENESTAR -
¿Cómo realizar el índice tobillo-brazo?

Indice tobillo-brazoEl índice tobillo-brazo es un parámetro que muestra la relación existente entre la presión arterial sistólica de extremidades superiores y l... Leer el resto
Publicado el 24 agosto 2012 SALUD Y BIENESTAR -
¡Tengo Dolor de Oído!

Dolor de OídoLa mayoría de las otalgias (dolor de oído) primarias se pueden diagnosticar tras una adecuada anamnesis (interrogatorio) y exploración otoscópica. Leer el resto
Publicado el 23 agosto 2012 SALUD Y BIENESTAR -
Infección por Escherichia coli (E. coli)
Cultivo de Escherichia coli (E. coli)La Escherichia coli, también conocida como E. coli, Se trata de una enterobacteria que se encuentra generalmente en los... Leer el resto
Publicado el 13 agosto 2012 SALUD Y BIENESTAR -
¿Cómo puede afectar el calor a nuestra salud? Consejos

El calor puede afectar la salud¿Cómo afecta el calor a nuestra salud?Los días de calor intenso en el verano, obligan a nuestro cuerpo a realizar un esfuerzo de... Leer el resto
Publicado el 11 agosto 2012 SALUD Y BIENESTAR -
El Síndrome de ordenamiento coronario, puente intramiocárdico o “milking”

Ordenamiento coronario, puente intramiocárdico o “milking”El Síndrome de ordenamiento coronario, puente intramiocárdico o “milking”Es la compresión sistólica... Leer el resto
Publicado el 09 agosto 2012 SALUD Y BIENESTAR -
¡Una siesta cada día!

Siesta después de la comida Mucho se ha discutido sobre los benéficos que produce tener una siesta después de la comida, por este motivo he realizado una... Leer el resto
Publicado el 06 agosto 2012 SALUD Y BIENESTAR -
Dolor de garganta: ¿Cuándo tomar antibióticos?

Dolor de Garganta y FiebreDolor de garganta (Faringitis, Amigdalitis) Una de las consultas más frecuentes en atención primaria es el dolor de garganta... Leer el resto
Publicado el 03 agosto 2012 SALUD Y BIENESTAR -
¿Cuántos pasos hay que dar al día? (caminar)

Tenemos que caminar 10.000 pasos al día¿Cuántos pasos hay que dar al día? (caminar)Los pacientes generalmente se preocupan por si dieta y por el ejercicio, sin... Leer el resto
Publicado el 01 agosto 2012 SALUD Y BIENESTAR -
Dolor de muela por un Flemón Dental ¿Qué hacer?

Flemón Dental, Dolor de muelaTengo un dolor de muela por un Flemón Dental ¿Qué puedo hacer? Una casa frecuente de consulta es el dolor en las encías o dolor de... Leer el resto
Publicado el 30 julio 2012 SALUD Y BIENESTAR -
Tengo la TSH alta, y eso ¿Qué significa? Tiroides

Examen de la Tiroides, TSH elevada.Tengo la TSH alta, y eso ¿Qué significa?Tener un poco alta la TSH es un hallazgo muy frecuente en la consulta de atención... Leer el resto
Publicado el 29 julio 2012 SALUD Y BIENESTAR -
Alérgia en los ojos o conjuntivitis alérgica

Ojos cerrados, Alergia en los Ojos, Conjuntivitis alérgicaConjuntivitis alérgica, alergia en los ojos u ojo rojo alérgico.Es un motivo frecuente de consulta en... Leer el resto
Publicado el 25 julio 2012 SALUD Y BIENESTAR -
La cervicalgia o dolor en cuello, enfoque médico

Dolor en el Cuello, Cervicalgia, Contractura Muscular La Cervicalgia o Dolor en el Cuello, es una dolor por inflamación en cualquiera de las estructuras... Leer el resto
Publicado el 23 julio 2012 SALUD Y BIENESTAR -
Dieta baja en sal para la hipertensión arterial

Dieta baja en Sal para la Hipertensión ArterialSe establece que el consumo de sal en las personas no debe superar los 6 gramos al día para evitar los... Leer el resto
Publicado el 22 julio 2012 SALUD Y BIENESTAR -
Dolor crónico, la peor secuela del Herpes Zoster

Cambio de Piel, Herpes ZosterTodas las personas que han pasado la varicela crean anticuerpos contra el virus. El virus luego se acantona durante años en la... Leer el resto
Publicado el 21 julio 2012 SALUD Y BIENESTAR -
Ardor o escozor al orinar (hacer pipí)

Ardor o escozor al orinar "Doctor desde hace 3 días tengo muchas ganas de ir al baño a orinar, a cada rato, y tengo que ir rápido y cuando llego hago muy poco... Leer el resto
Publicado el 20 julio 2012 SALUD Y BIENESTAR -
¿Cuanto ejercico debo hacer?

Ejercicio en Bicicleta al amanecer¿Cuanto ejercico debo hacer? o ¿Cal es la cantidad de ejercicio que me corresponde? son preguntas que escuchamos frecuentement... Leer el resto
Publicado el 19 julio 2012 DEPORTES, SALUD Y BIENESTAR -
Ventajas de la lactancia materna
Lactancia Materna, Dando pecho, Beneficios.Según la OMS (Organización Mundial de la Salud) la leche materna es el mejor alimento que la madre puede ofrecer al... Leer el resto
Publicado el 19 julio 2012 MATERNIDAD
